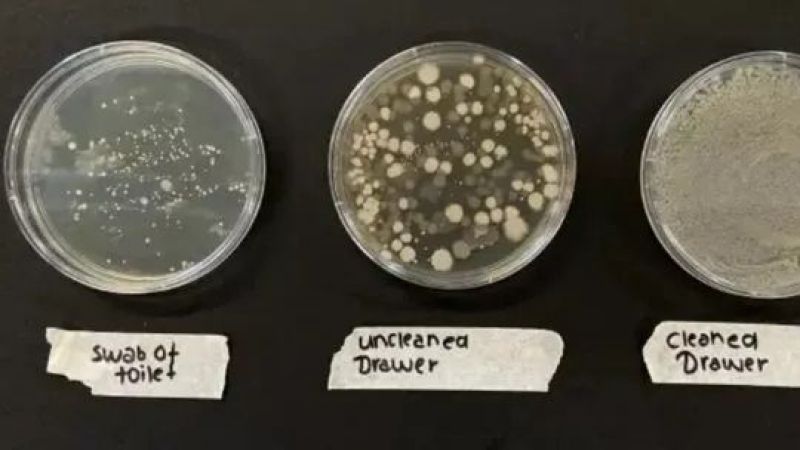
Cilt Bakımında Yapılan Yanlış! Üstünde Bulunan Bakteriler Klozet Kapağında Bulunandan Daha Çok! 3

Cilt Bakımında Yapılan Yanlış! Üstünde Bulunan Bakteriler Klozet Kapağında Bulunandan Daha Çok!

 13
13
Ciltte meydana gelen sivilce bir gün siyah nokta ve akne sorunlarına sebep olan birçok etken bulunmakta. Bu cilt problemlerinin ortadan kaldırmak adına çeşitli yöntemler aranıyor. Evde farkında olmadan yapılan bir yanlış bütün cilt sorunların oluşmasına sebep olabiliyor. Yapılan araştırmalar cildimize uyguladığımız bu malzemenin tuvaletten daha çok bakteri içerdiğini ortaya koydu.
Foto Haber ve Resimleri Görmek İçin Diğer Sayfaya Geçiniz...
 23
23
Makyajın cildimiz ile daha çok bütünleşmesini sağlamak için makyaj fırçasıyla sünger kullanıyoruz. Bu ürünler daha profesyonel aynı zamanda doğa sonuçlar sağlasa da cilt için zararlı olabiliyor. Yeni yapılan bir çalışmada yıkanmamış fırçalardan biriken korkunç miktarda bakteri olduğunu ortaya çıkmış oldu. bu bakterilerin klozet kapağında bulunmakta olan bakterilerden daha çok olduğu öğrenildi.
Foto Haber ve Resimleri Görmek İçin Diğer Sayfaya Geçiniz...
33
33
Araştırmacılar, 2 haftalık deneme süresinin sonrasında temiz ve ‘kirli’ makyaj fırçalarını temizlerken aynı zamanda çeşitli yaygın saklama yöntemlerine daha iyi test yaptılar; yatak odasında bulunan makyaj masasında, makyaj çantasında, Banyo askısı ile çekmecede. Sonuçları bir klozet kapağının temizleme beziyle karşılaştıran bahsi geçen çalışma fırçaları nerede saklanıyor olursa olsun, bakteri sayısının tuvalet ile aynı ya da daha fazla olduğunu ortaya koydu. Kozmetik bilimci olan Carly Musleh, makyaj fırçalarının bakterileri, ölü deri hücreleri ile yağı yüzden ürüne aktara bildiğini ifade etti. Her tür bakteri mutlaka zararı olmuyor olsa da rutin olarak kıllı fırça kullanımı yapmak sivilce ya da daha kötü sonuçlara sebep olabiliyor.
DÜZENLİ OLARAK TEMİZLİK ŞART
Kirli fırçalarının kullanılması, sağlık ve mikrobiyel toplulukta bir dengesizliğe sebep olma riskini artırabilir ve patlamalara ya da impetigo ya da Staph enfeksiyonları gibi daha ciddi problemlere sebep olabilecek patojenik mikropların sayısında artışa neden olabilir açıklaması yapıldı. ‘Bakteri oluşumunu aza indirmek için makyaj fırçalarını düzenli olarak temizlemek önemli bir noktadır.
Türkçe karakter kullanılmayan ve büyük harflerle yazılmış yorumlar onaylanmamaktadır.